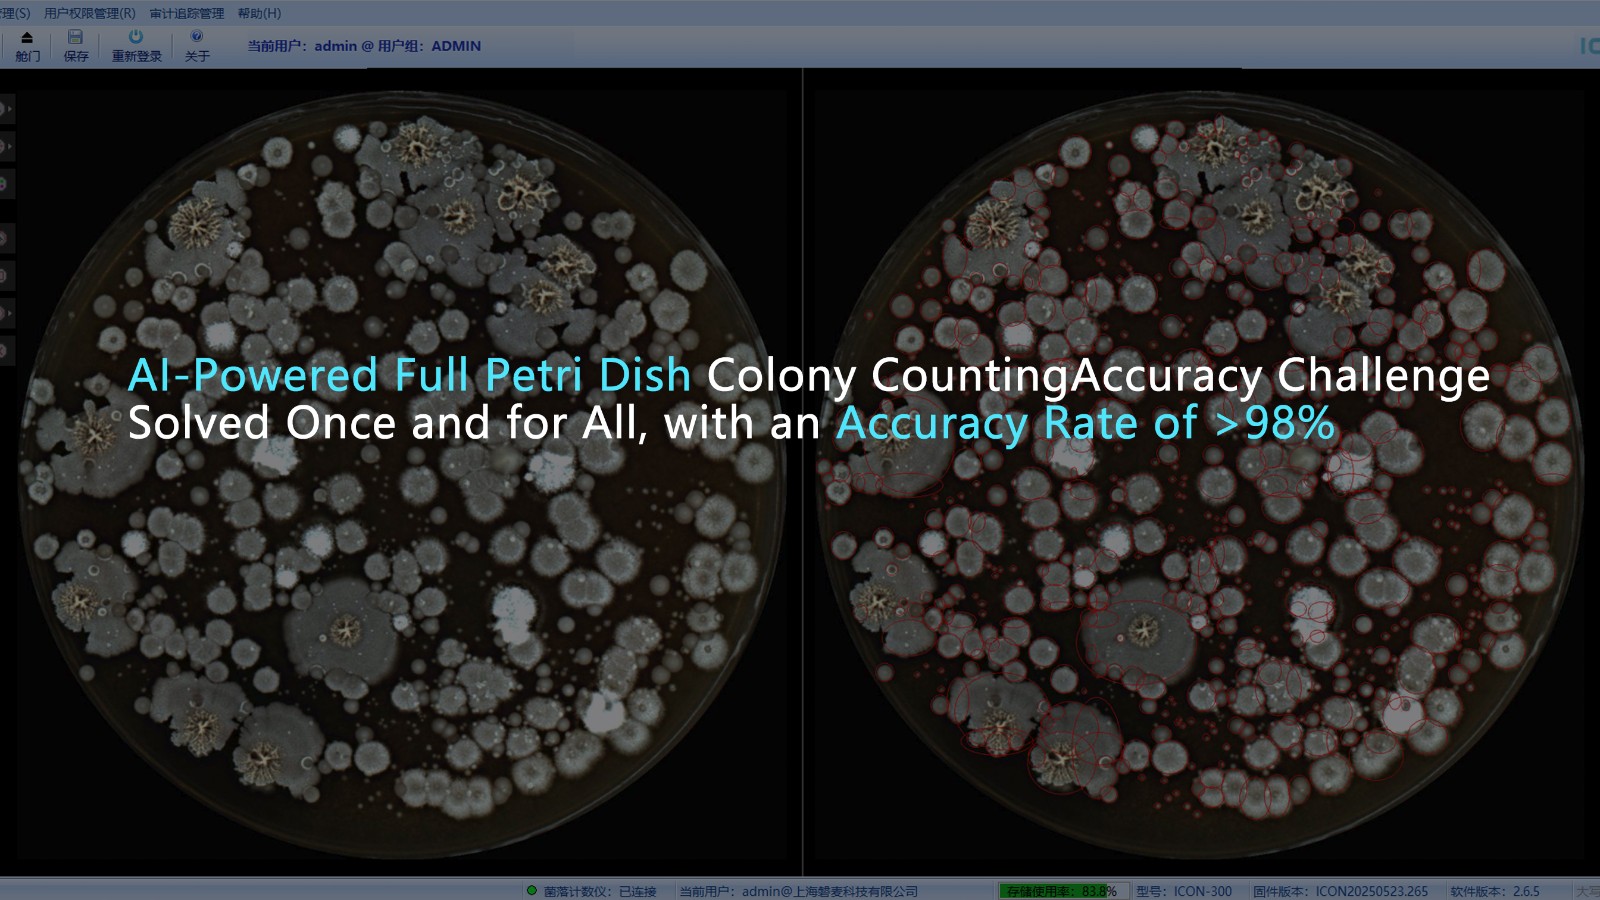
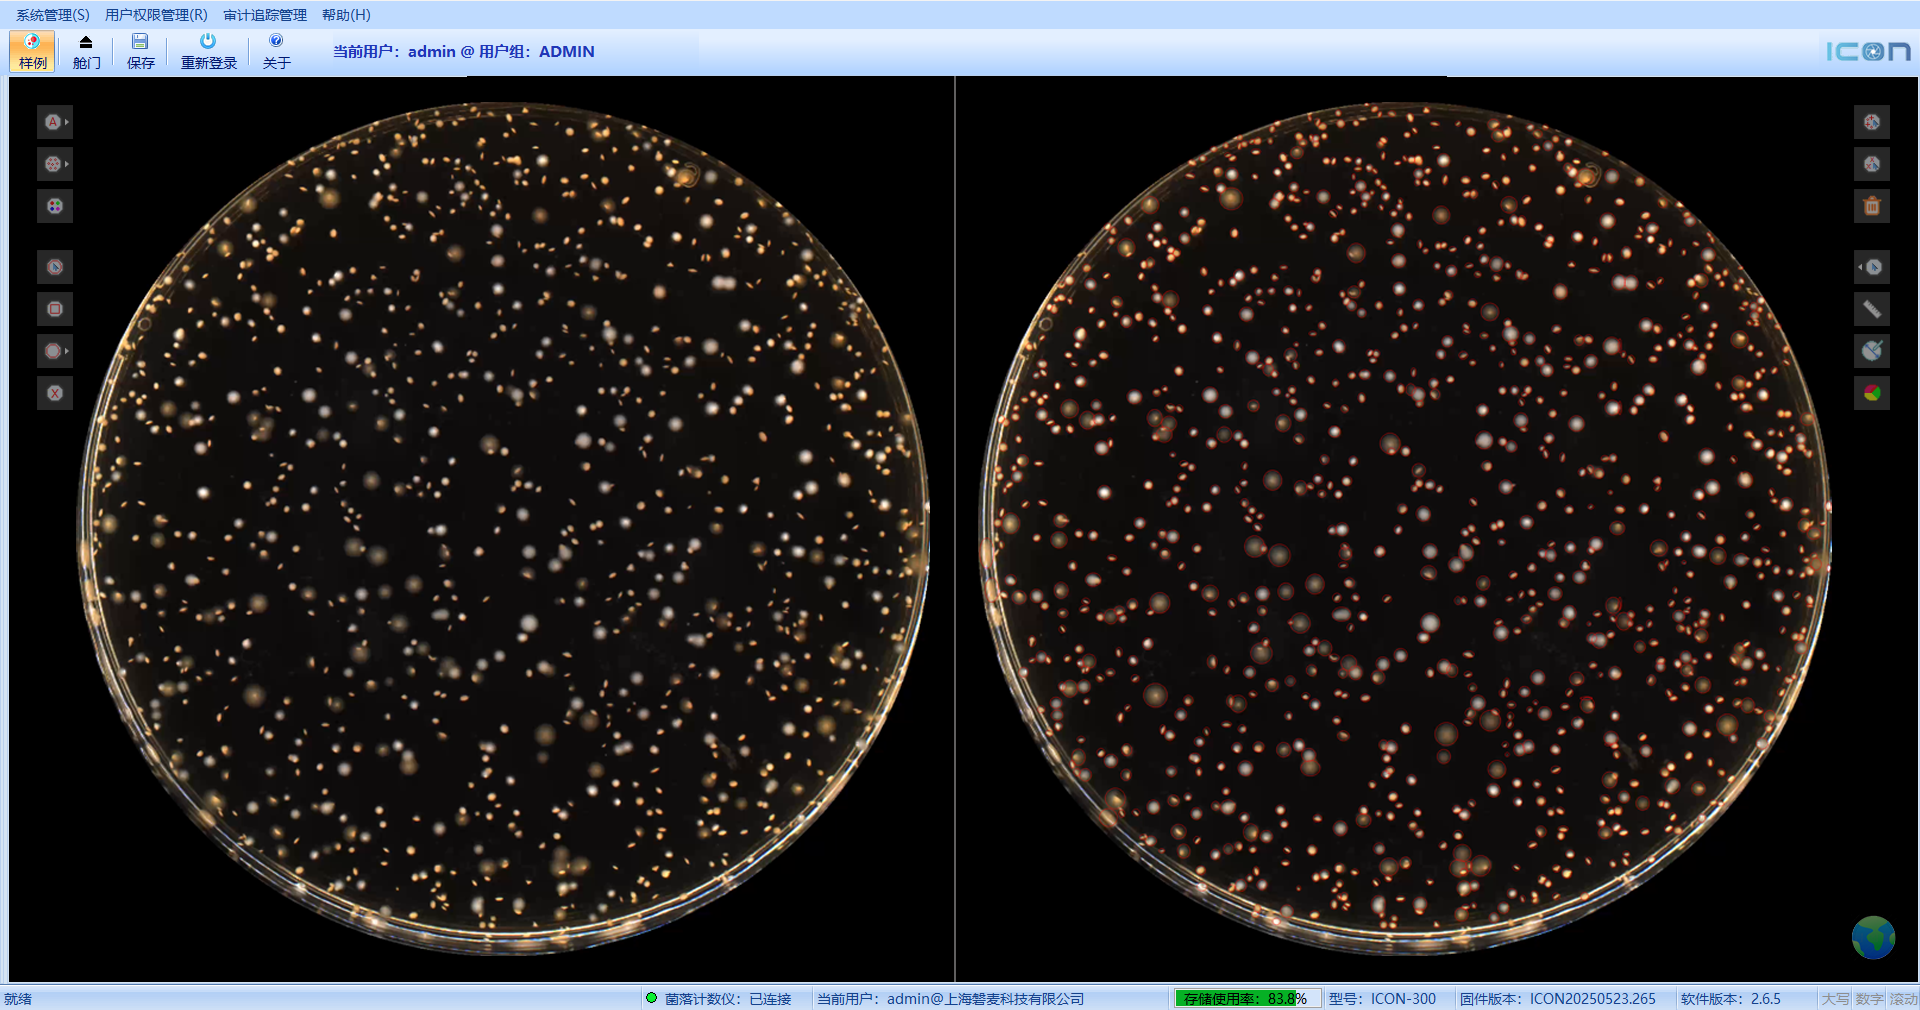
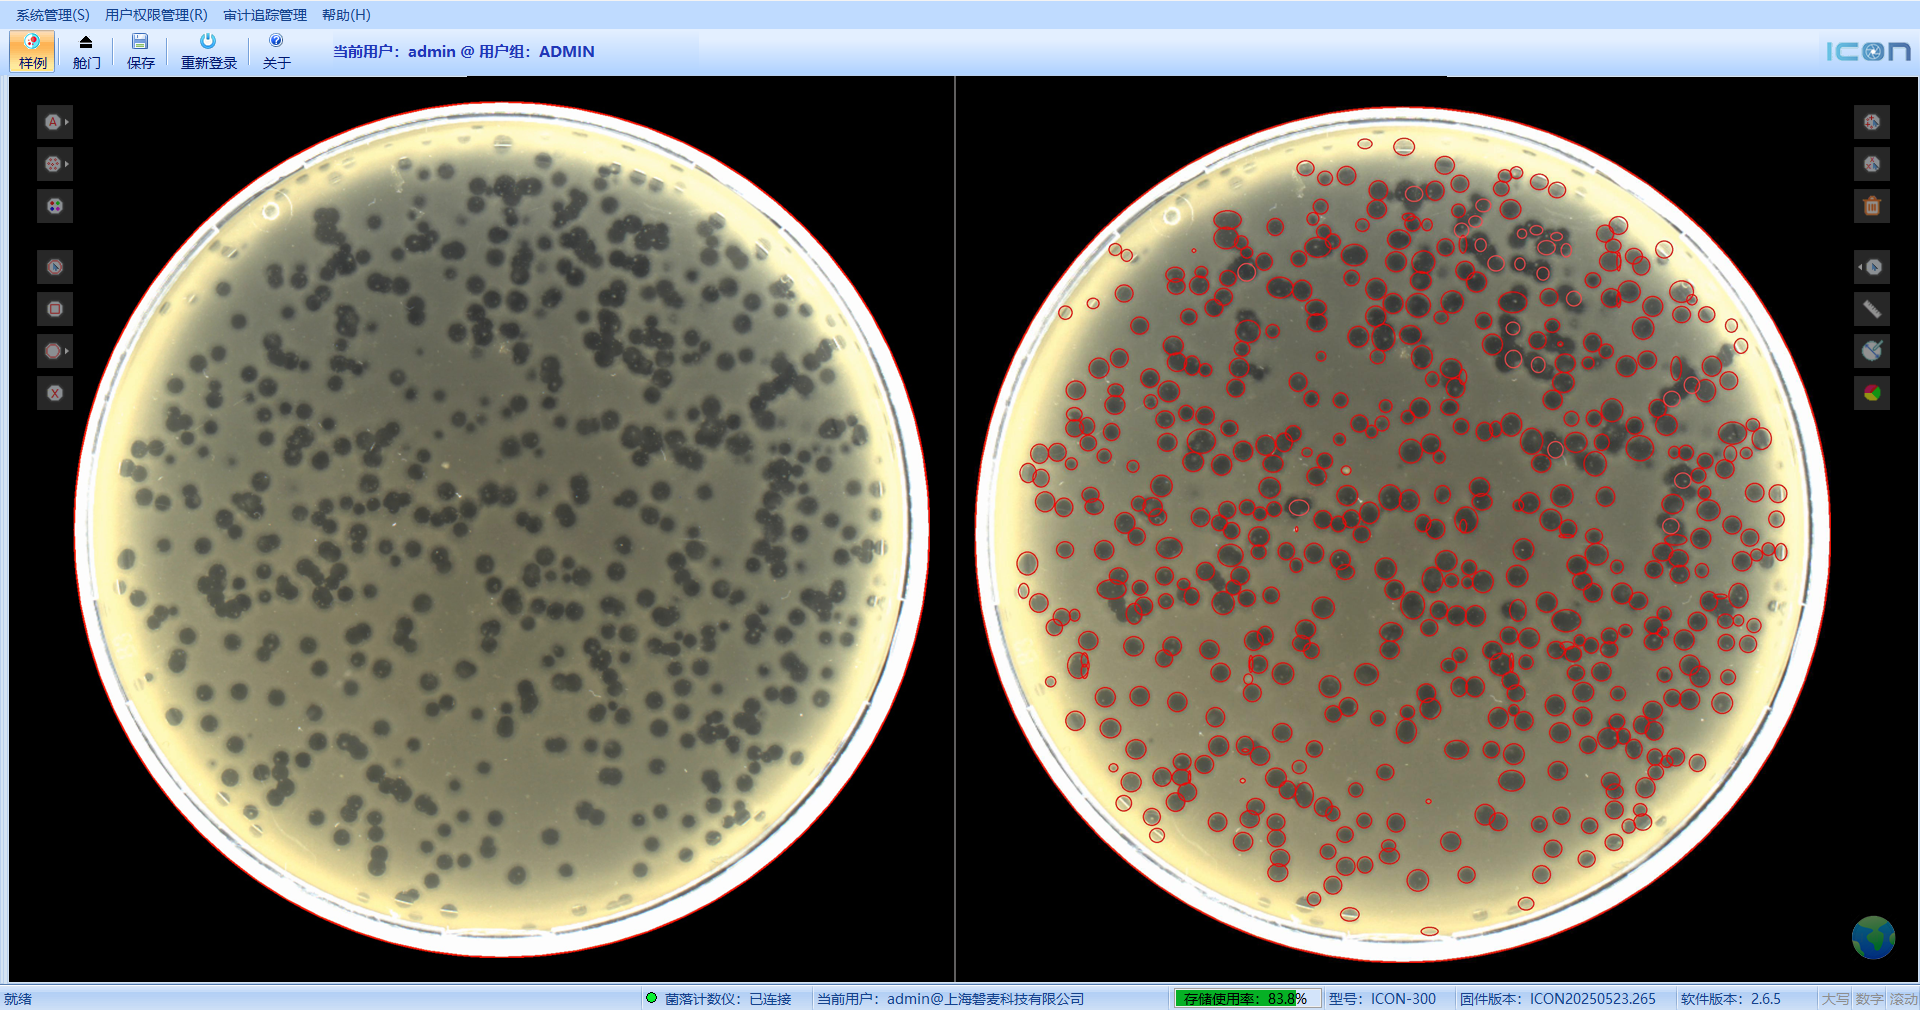
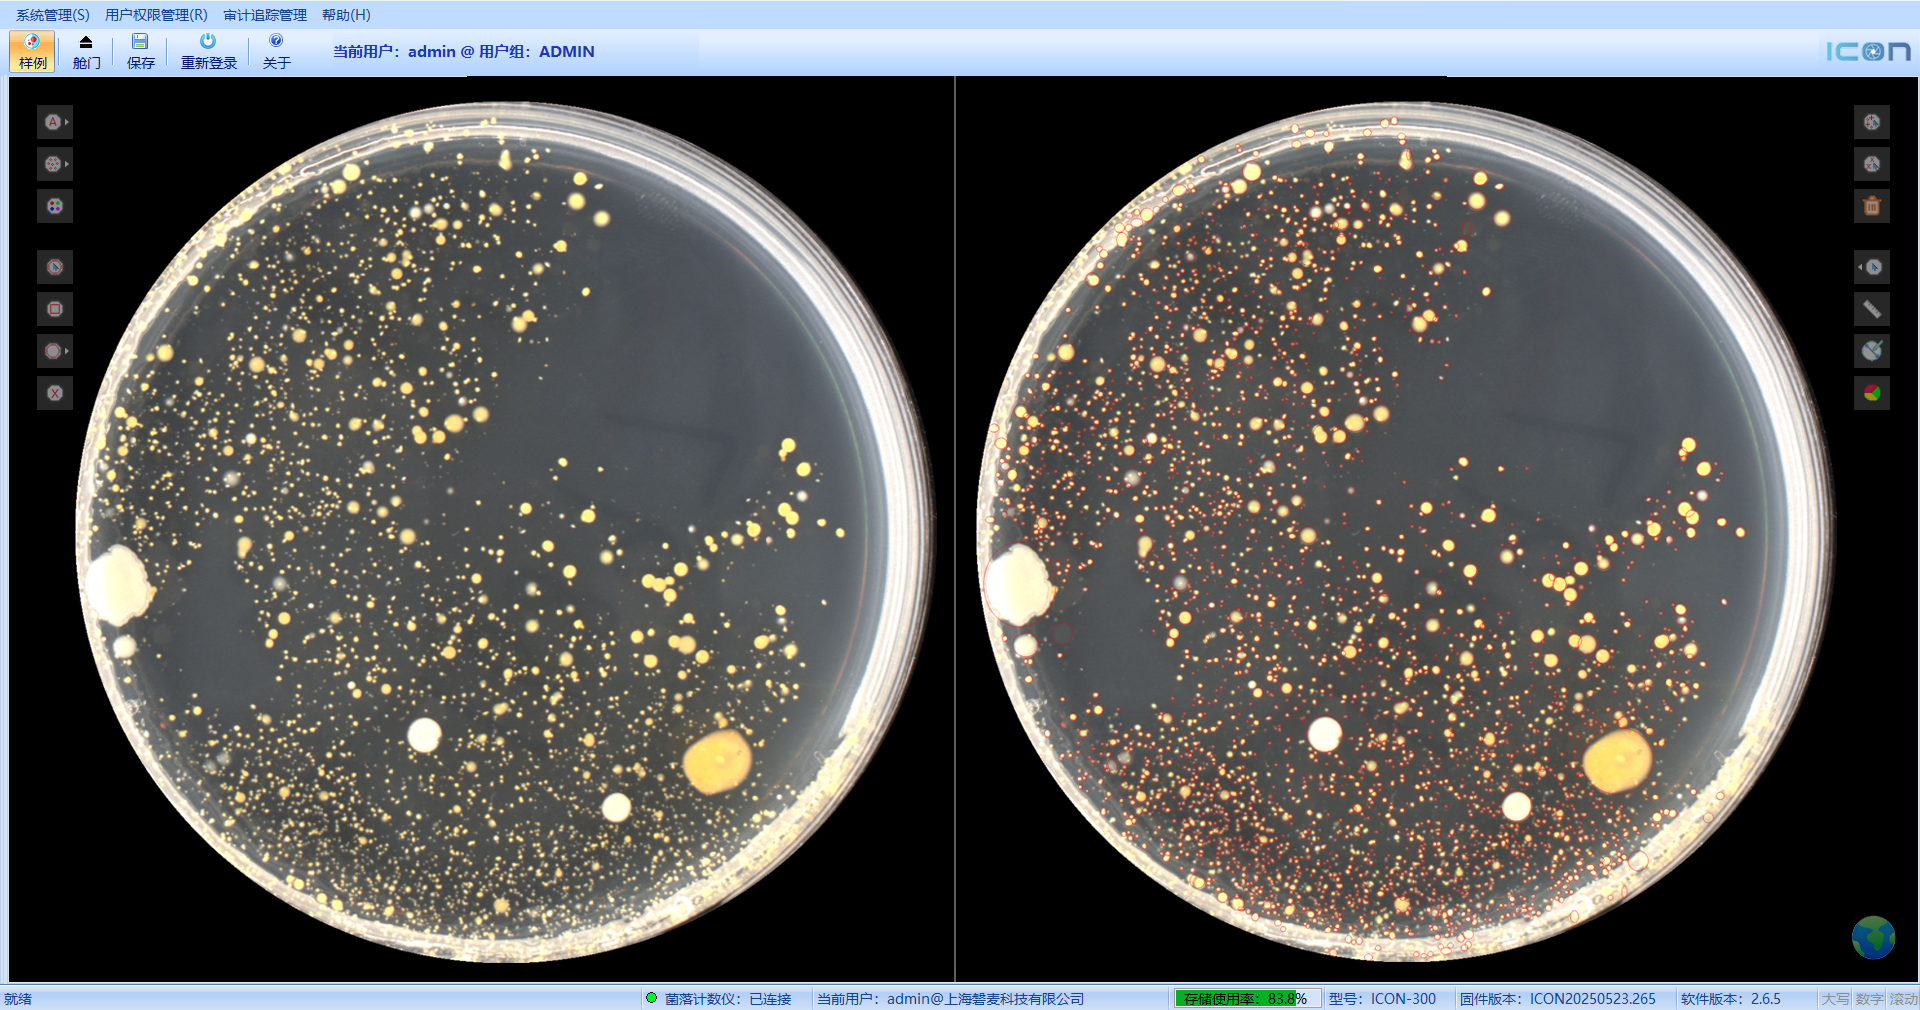
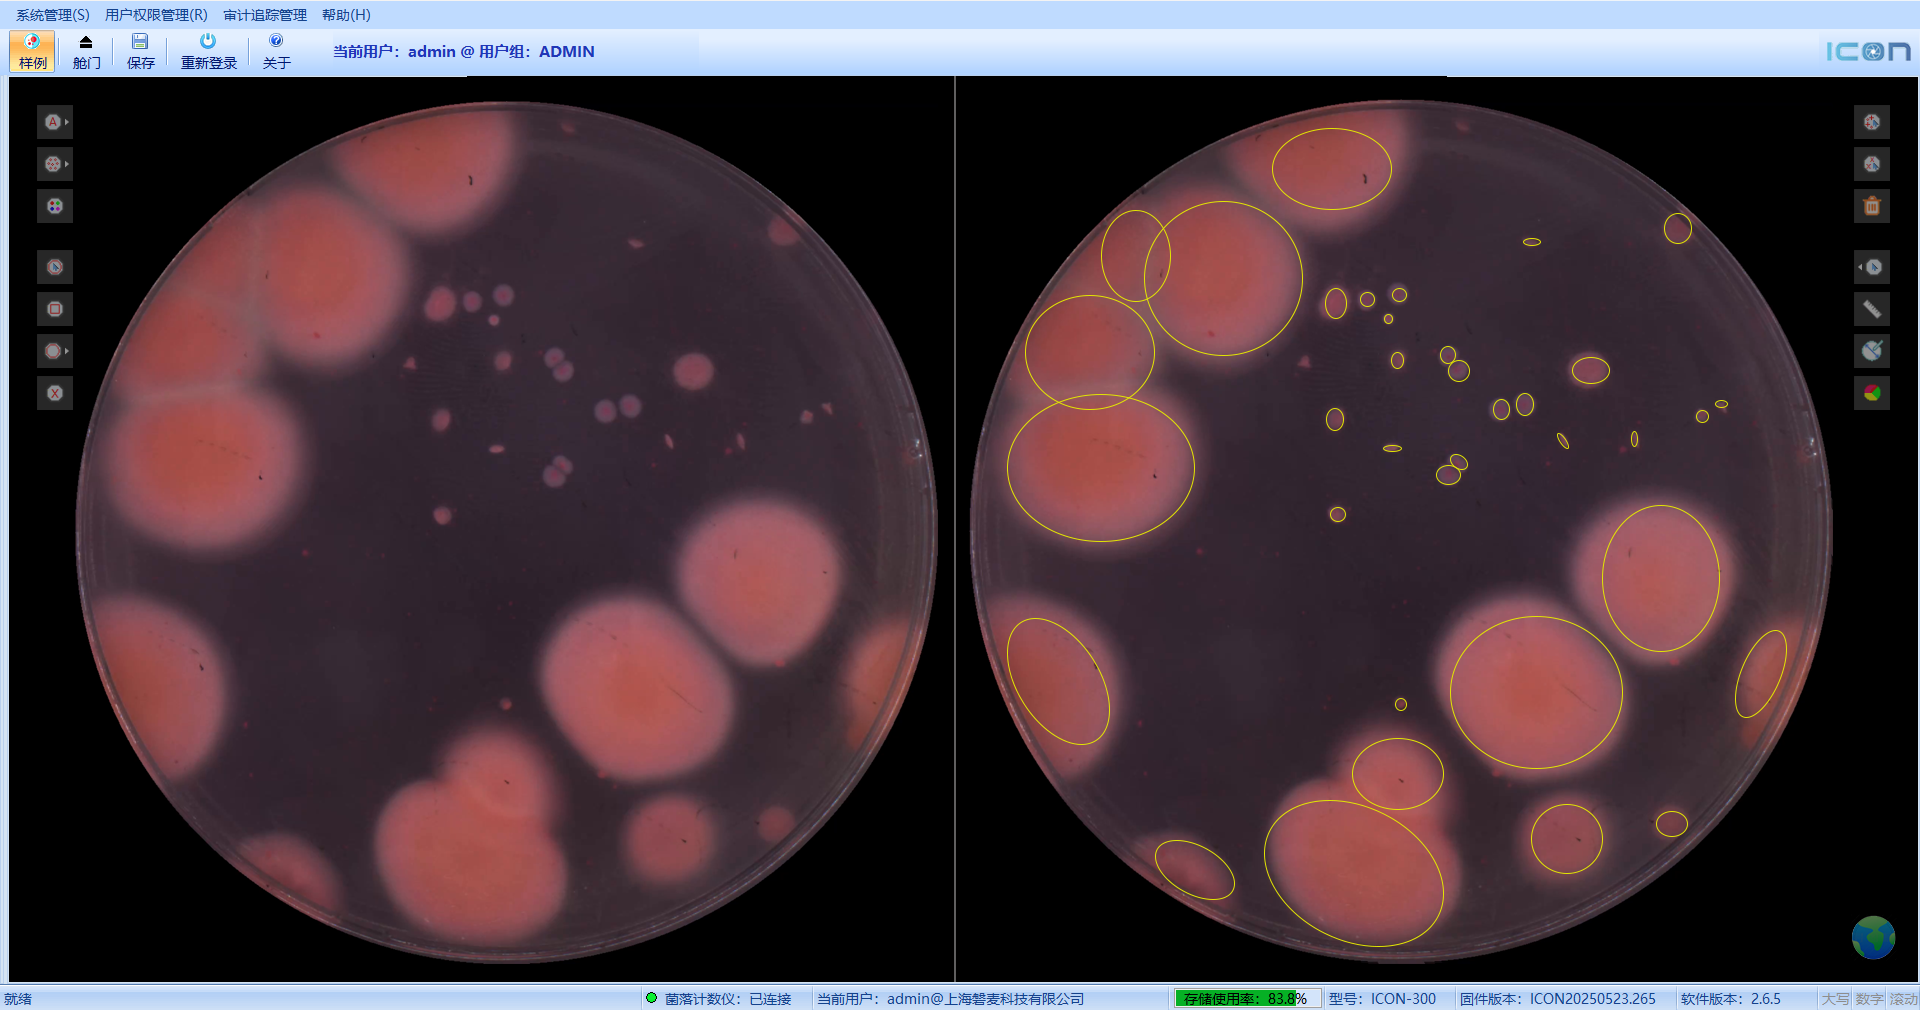
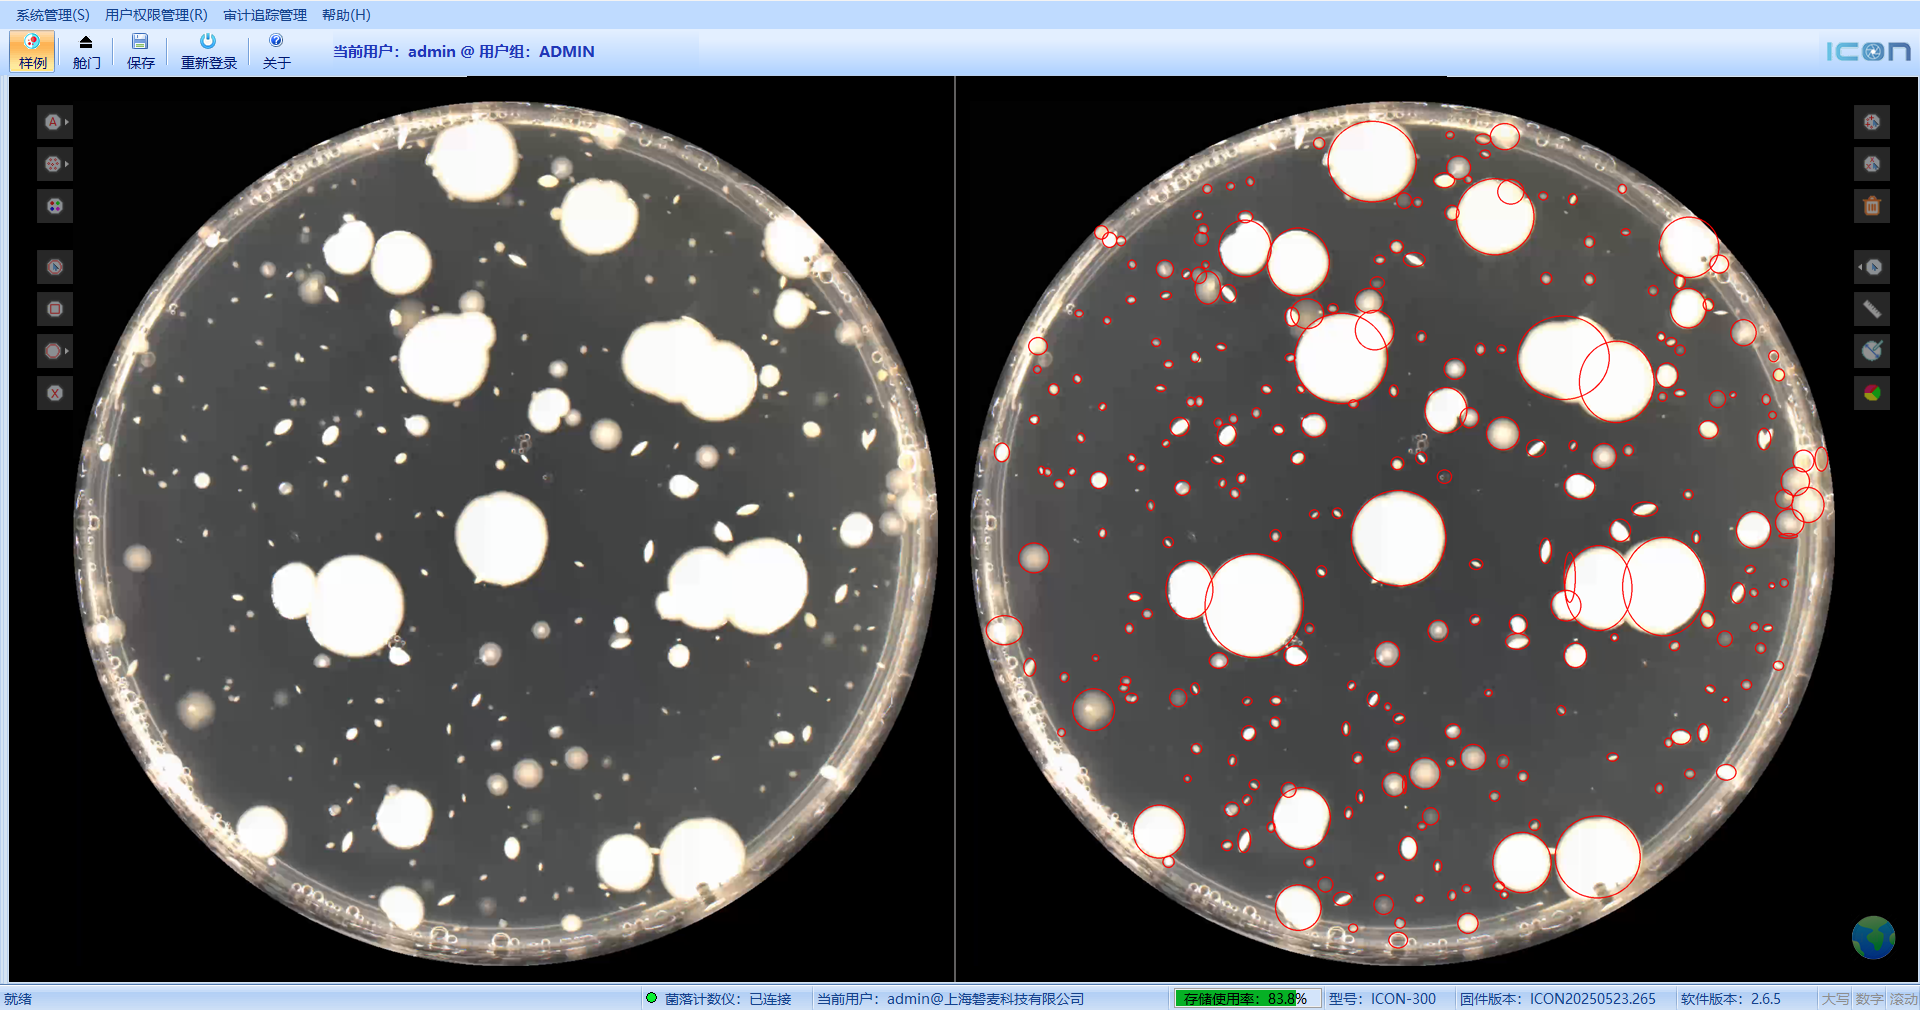
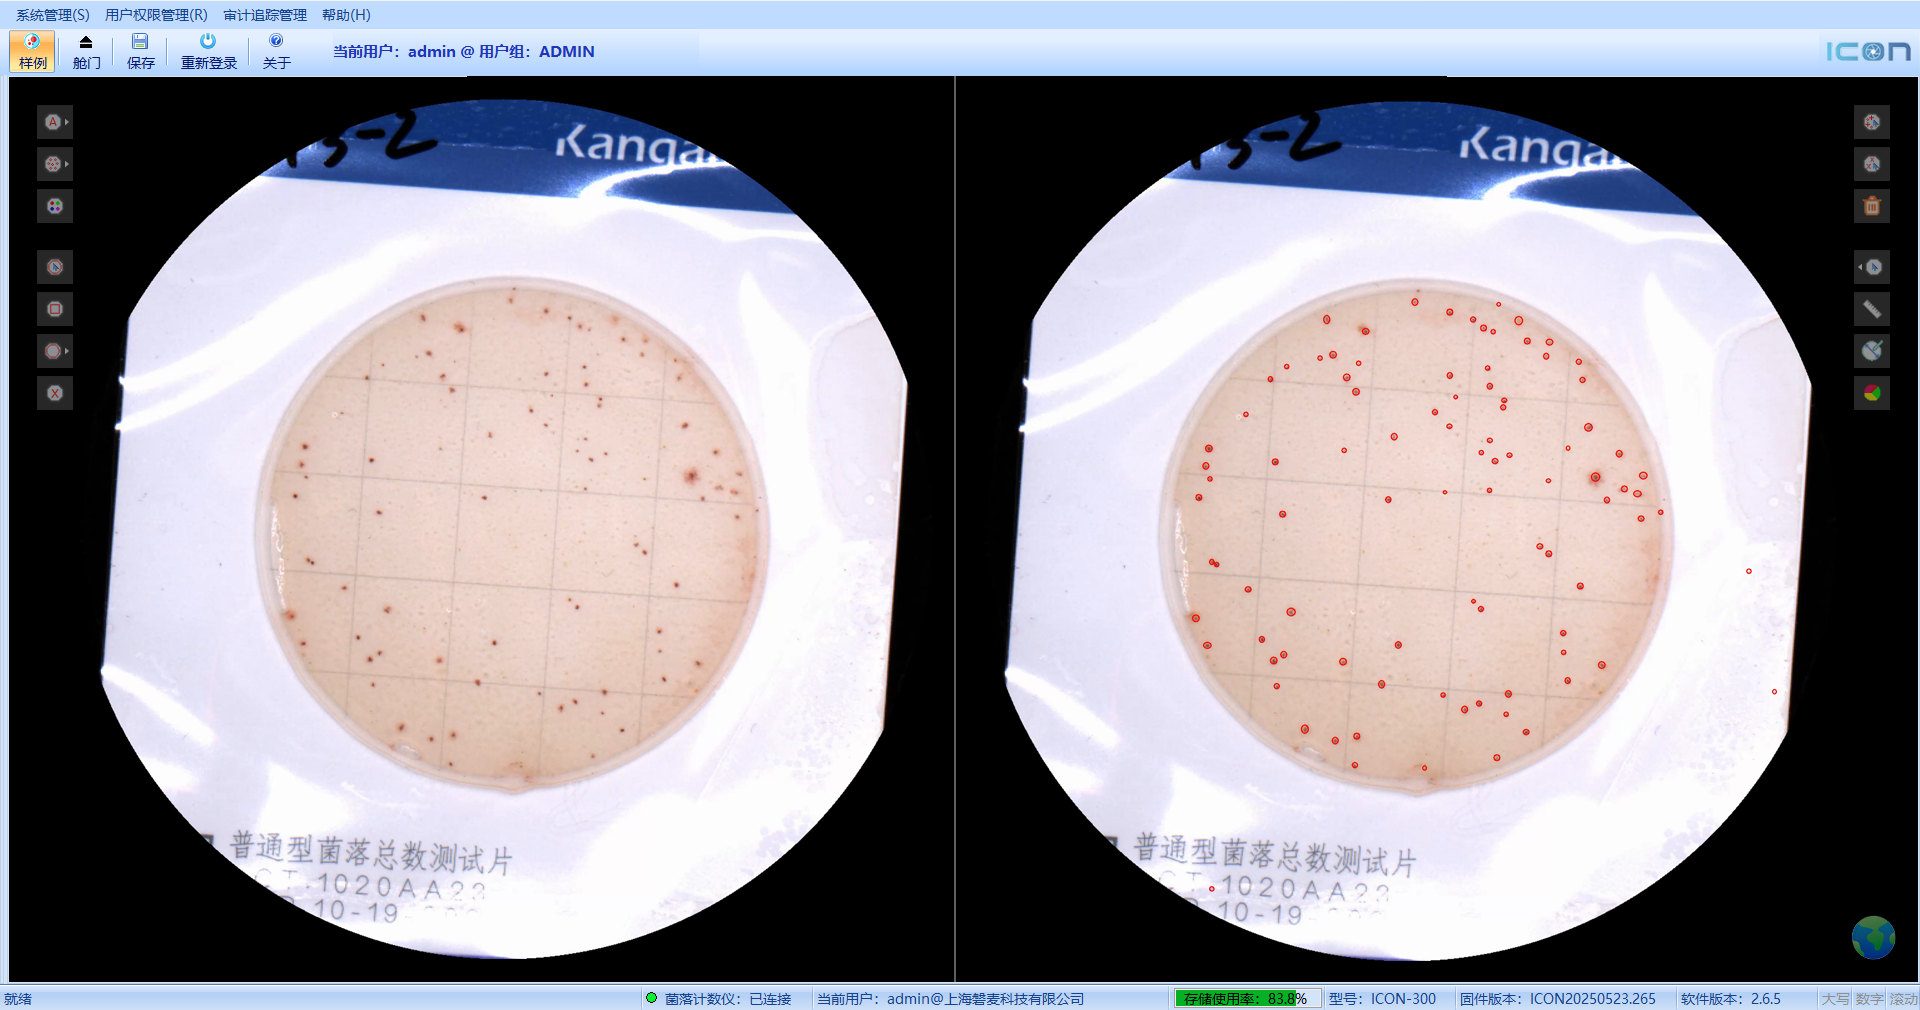

Automatic colony counter


Extremely simplified software settings interface, no need to manually set mechanical switches and complicated pre selection parameters, one click analysis, fastest counting in 3 seconds

AI algorithms actively learn and train unfamiliar colony forms, resulting in faster and more accurate colony counting with an accuracy rate of over 98%

Open Application Programming Interface (API) allows for arbitrary connection of external robotic arms

Computing system |
Embedded computing system, with the computing core built into the host to avoid damage caused by abnormal factors such as computer viruses |
software system |
Manual correction supports region selection, region reverse selection, single addition, single deletion, and supports pre selection of multiple regions for simultaneous counting and analysis |
Counting type |
Support spiral coating method, pouring method, paper sheet method, membrane filtration method, contact disc counting, glove embossing counting, etc |
Colony recognition |
Capable of distinguishing impurities, bubbles, adherent colonies, irregular colonies, and overlapping colonies |
Sample Specifications |
60mm/90mm/120mm/150mm standard circular culture dish, automatically recognized by the system |
light source |
Built in top and bottom light sources, no need for mechanical switch control, automatic dimming, 254nm UV lamp for sample chamber disinfection (optional), 366nm UV lamp for fluorescence based colony counting (optional) |
sample warehouse |
Fully concealed sample compartment, electric compartment door |
data transmission |
Gigabit Ethernet or WIFI wireless data transmission |

product
resource
News application
Contact Us
©2025 Punmicro scientificCopyright